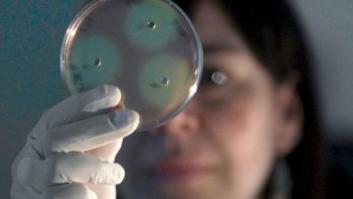
No dejes de ayudar. 11 ejemplos de que la implicación social es clave para la investigación

Comprobar Lotería Nacional hoy sábado 7 de junio en directo: números del sorteo extraordinario contra el cáncer AECC 2025
Sigue el sorteo extraordinario de la AECC 2025 de Lotería Nacional en directo hoy sábado 7 de junio, en el que se pone en juego un primer premio de 1,5 millones de euros a la serie, 150.000 euros al décimo.